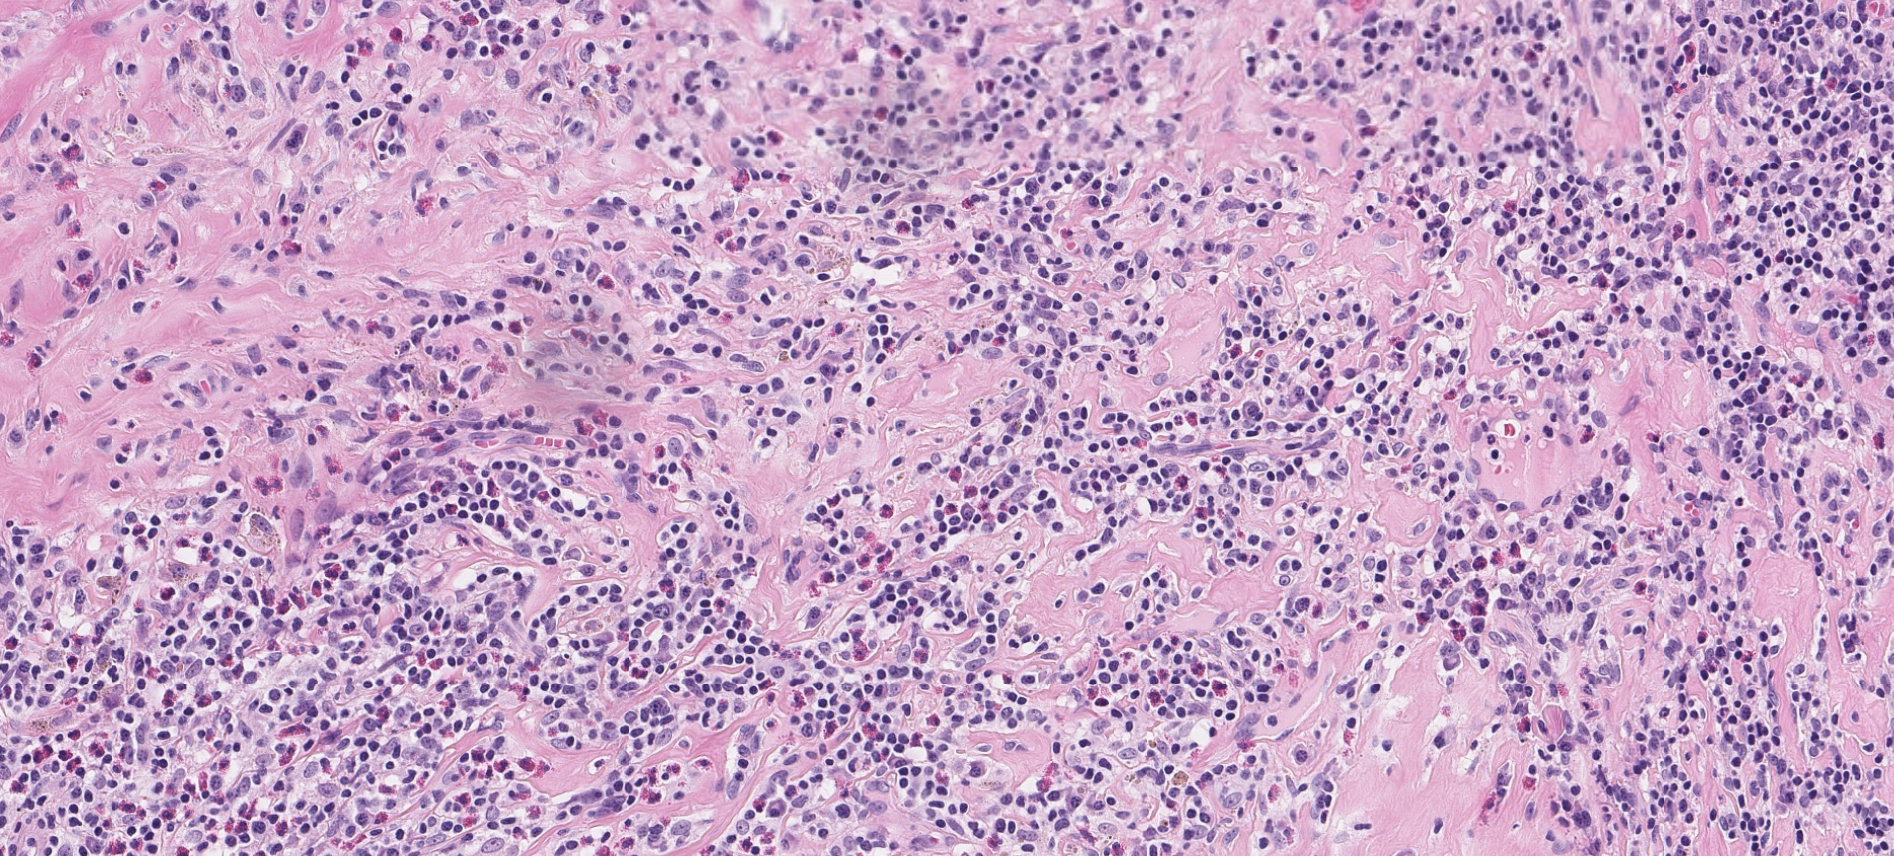

Leeds Lymphoma Course: Winter 2025
WHO SHOULD ATTEND:
Whether you are UK-based or overseas, seeking guidance with everyday cases , reviewing for exams or aspiring heamatopathology as a sub-speciality, this course is for you.
COURSE FORMAT:
The short webinar series is designed in a friendly format. The sessions are delivered online via Zoom.
Despite its virtual nature, the course is very much interactive with cases discussions and Q&As.
After the course, you will be provided with access to recorded sessions for a limited time.
Approved by RCPath for CPDs